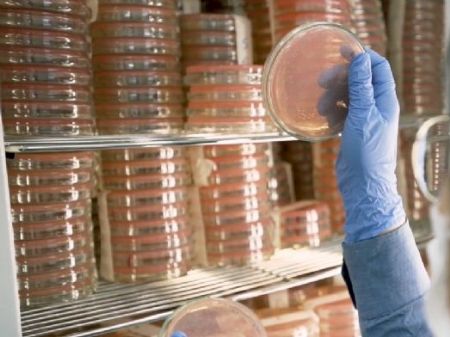

PUBLICIDADE
- mell280
30/11/2025 07h18
Domingo será quente, com possibilidade de chuva e rajadas de vento
Campo Grande começou o dia com termômetros marcando 26°C, mas a temperatura pode chegar a 35°C
Por Ana Paula Chuva
Campo Grande deve ter um domingo (30) marcado por calor intenso, variação de nebulosidade e possibilidade de pancadas de chuva no fim da tarde e à noite, conforme previsão divulgada pelo Cemtec (Centro de Monitoramento do Tempo e do Clima de Mato Grosso do Sul).
De acordo com o boletim, as temperaturas na Capital devem variar entre 23 °C e 25 °C nas primeiras horas do dia, chegando a 34 °C ou 35 °C durante a tarde. O tempo tende a começar estável, com sol predominante e céu parcialmente aberto, mas o aumento da umidade e a atuação de instabilidades atmosféricas podem favorecer a formação de nuvens carregadas ao longo do período.
Além da chance de pancadas isoladas, o domingo também pode registrar ventos moderados a fortes, soprando entre os quadrantes leste e norte, com velocidades de 40 a 60 km/h e possibilidade de rajadas superiores a esse intervalo.
Na região pantaneira, cidades como Corumbá e Aquidauana devem registrar máximas próximas de 39–40 °C. Já no Bolsão, Três Lagoas e Anaurilândia podem ter picos de até 40 °C.
Para o norte do Estado, a previsão também é de calor intenso. Em Coxim, as temperaturas devem variar entre 21 °C e 23 °C (mínima) e entre 35 °C e 37 °C (máxima). Na porção sul e no Cone Sul, região de Dourados, as mínimas ficam entre 20 °C e 23 °C, e a máxima chega aos 39 °C.
Domingo terá calor de até 40°C em MS e chance de temporais isolados à t... veja mais em